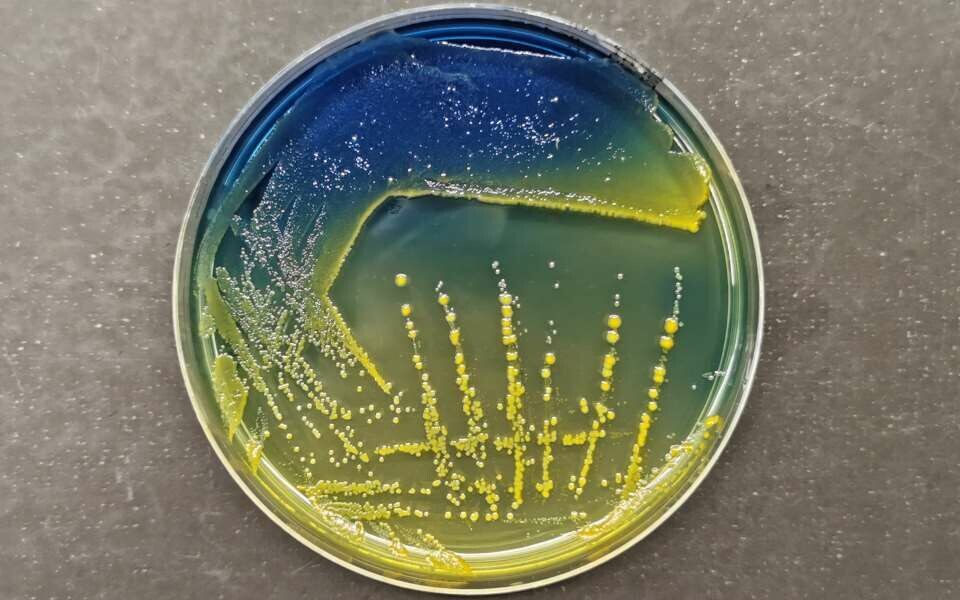

Aktuelt
Hypervirulent Klebsiella pneumoniae på fremmarsj i Europa
Ifølge en ny risikovurdering er det moderat fare for spredning i norske helseinstitusjoner.
K. pneumoniae kan deles inn i to patotyper, klassiske K. pneumoniae (CKp) og hypervirulente K. pneumoniae (HvKp). Førstnevnte rammer eldre med nedsatt immunforsvar og underliggende sykdom, mens sistnevnte er assosiert med atypiske alvorlige infeksjoner hos ellers friske, uavhengig av alder.
Det europeiske smitteverninstituttet (ECDC) har kommet med en risikovurdering av spredningen av hypervirulente K. pneumoniae (HvKp) ST23 med karbapenemasegener* i Europa. Bakteriene har spredd seg mellom helseinstitusjoner i Irland, og klynger er oppdaget i flere europeiske land. Det er høy sannsynlighet for ytterligere spredning og etablering av HvKp med karbapenemasegener i helsevesenet i EU/EØS-land.
Den norske risikovurderingen konkluderer med moderat sannsynlighet for slik spredning i Norge. Det er identifisert fem karbapenemase-produserende HvKp ST23 i Norge, alle assosiert med import fra Ukraina.
Spredning av HvKp uten karbapenemasegener er imidlertid også bekymringsfullt, på grunn av de sykdomsfremkallende egenskapene.
Mikrobiologisk påvisning av HvKp er utfordrende, og foreløpig vil helgenomsekvensering være nødvendig for å kunne analysere bredden av virulensfaktorer, står det i risikovurderingen.
De som har gjort vurderingen er Folkehelseinstituttet, Nasjonalt kompetansesenter for påvisning av antibiotikaresistens (K-res), Avdeling for medisinsk mikrobiologi, Stavanger universitetssjukehus og NORM - Norsk overvåkingssystem for antibiotikaresistens hos mikrober.
Risikovurdering av hypervirulente Klebsiella pneumoniae i Norge (pdf)
*Karbapenemaseproduserende bakterier (CPO) har mekanismer som gjør dem resistente mot bredspektret antibiotika.